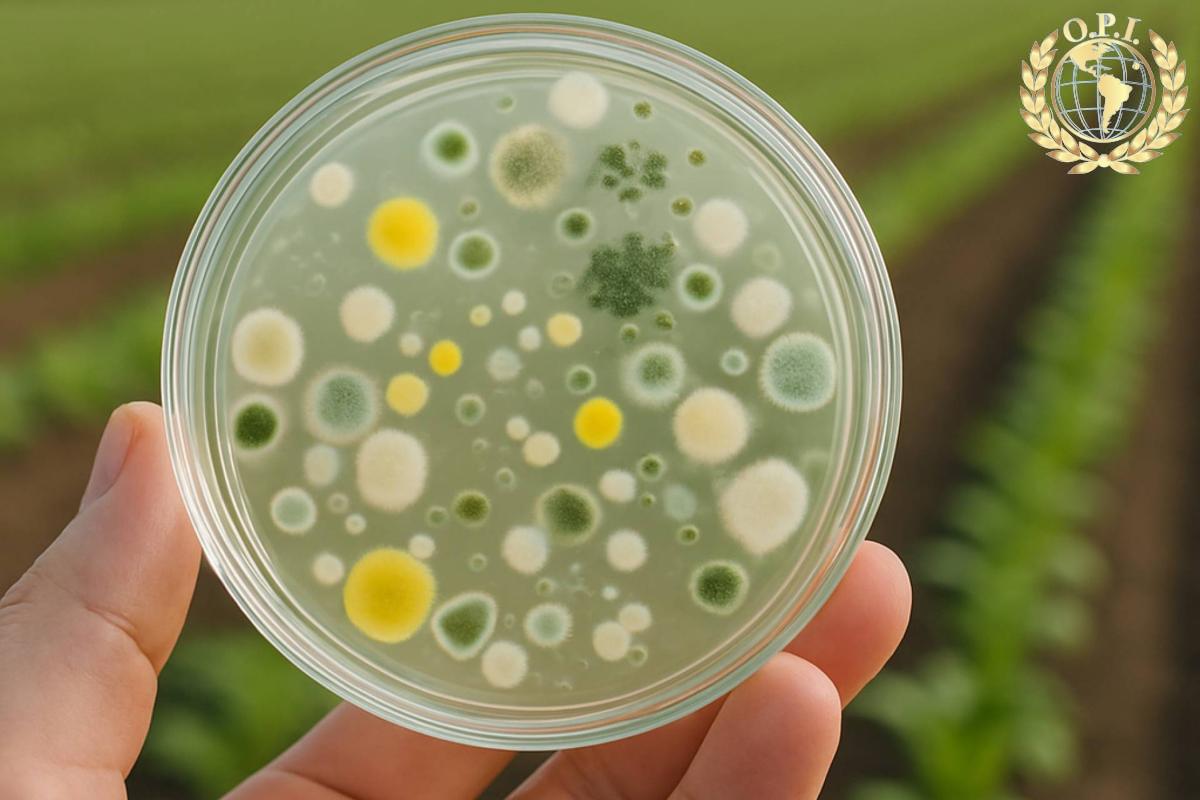

Artículos diarios: 14 septiembre, 2025

Centro de Fomento del Libro en Latinoamérica: «Perder la lectura es perder derechos»
septiembre 14, 2025
Barcelona (España), 14 sep.- La directora del Centro Regional para el Fomento del Libro en América Latina y el Caribe (Cerlalc), Margarita Cuéllar, advierte en una entrevista con EFE de que la «pérdida» del...

La nueva producción del español Trueba, un recorrido por escenarios de Brasil y Nueva York
septiembre 14, 2025
Cádiz (España), 14 sep.- El director Fernando Trueba, uno de los cineastas españoles más internacionales y laureados, ha sido uno de los protagonistas de la tercera edición del South International Series Festival de Cádiz...

Escritor Javier Peña: «Los últimos días de tu padre siempre tienen un interés literario»
septiembre 14, 2025
Ciudad de México, 14 sep.- Recordar y narrar historias de grandes escritores como Juan Rulfo o Elena Garro fue lo que unió al español Javier Peña con su padre cuando «estaba en sus últimos...

Efemérides del 15 de septiembre
septiembre 14, 2025
En un 15 de septiembre, pero de 1935 en el VII Congreso del Partido Nazi en Núremberg (Alemania) se sentaron las bases para la persecución de los judíos, con la aprobación de las leyes...
Cómo ciertas bacterias contribuyen a proteger cosechas y a mejorar la calidad de los alimentos
septiembre 14, 2025
Parece ciencia ficción, pero es agricultura del siglo XXI. En los últimos años, miles de agricultores en España están incorporando microorganismos “buenos” a sus cultivos. Se trata de bacterias y hongos que no solo no dañan...

Los bosques amazónicos en tierras indígenas reducen la propagación de enfermedades
septiembre 14, 2025
Redacción Ciencia, 14 sep.- Los bosques amazónicos en tierras indígenas ayudan a reducir la propagación de enfermedades, así garantizar que esas comunidades tengan derechos sólidos sobre sus territorios es la mejor manera de mantener...

Los pulpos no usan los tentáculos indistintamente, cada uno tiene su función preferente
septiembre 14, 2025
Redacción Ciencia, 14 sep.- Los pulpos pueden usar cualquiera de sus tentáculos para realizar tareas, pero tienden a emplear uno o varios en concreto cuando se trata de misiones específicas, por ejemplo los delanteros...

Un pequeño fósil de 240 millones de años sería el miembro más antiguo de los lepidosaurios
septiembre 14, 2025
Redacción Ciencia, 14 sep.- Un pequeño fósil parecido a un lagarto procedente de Devon (Reino Unido), que data de hace unos 244-241,5 millones de años, podría ser el miembro más antiguo conocido del grupo...

Dr. Alexander J. Alfano, Reconocimiento internacional a una trayectoria jurídica ejemplar
septiembre 14, 2025
Por Álvaro Julio Martínez La Organización de Periodistas Iberoamericanos (OPI) presidida por la Dra. Tania Fernández de Toledo, otorgará un reconocimiento internacional al Dr. Alexander J. Alfano, destacado abogado y escritor, en una ceremonia...

Karol G canta por la fraternidad en un memorable macroconcierto en la plaza vaticana
septiembre 14, 2025
























